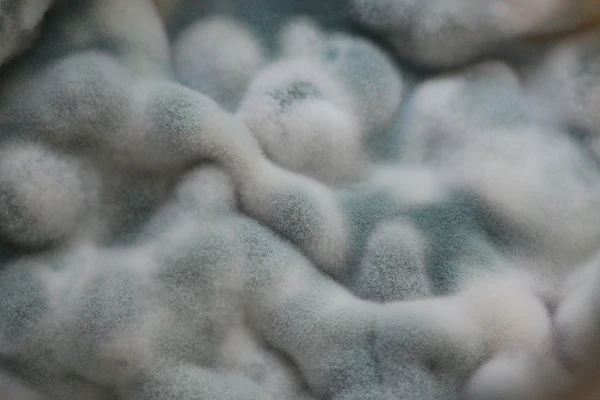
east and mold growing and limiting the shelf life of a particular dairy product

Get the most from your inputs in fermented milk production
Increase your yields, optimize your recipes and support extended shelf life. All with no compromise on the next-level quality your consumers love.
Get the most from your inputs
Wherever you are on your productivity journey, we can meet you there with the industry’s broadest dedicated biosolutions portfolio and largest technical service team. And with our complementary skills, we’ll get the most from your inputs. So you can power your profitability and accelerate your sustainability journey.

Yield improvement
Retain more protein through production with our starter cultures. They hold milk protein in the base so you can minimize your protein losses during whey separation. Which means you can achieve next-level yields in yogurt and quark production.

Recipe optimization
From high-texturizing starter cultures to probiotics and fermentation-enabled bioprotection, our biosolutions for recipe optimization help you give people texture, health benefits, shelf life and simpler labels that they’ll love.

Consistent quality
Consistent fermentation, low post-acidification, freshness through shelf life and minimal risk of phages or antibiotic residues. These are just a few of the ways we can help you achieve the consistent quality that people love.
Shelf-life extension
Help protect your products after they leave the warehouse and throughout their shelf life with fermentation-enabled bioprotection. Make them more robust in the face of cold chain and open packaging risks for next-level freshness.
Explore our biosolutions
Let’s get the most from your inputs together
Yield improvement, recipe optimization, consistent quality and longer shelf life. Fill out the form below and we’ll be in touch to explain how biosolutions can help with all these.
One more step…
To complete the get in touch form or sign up, please click on the button below to enable cookies.